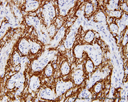

- Synaptophysin
Synaptophysin or synaptophysin can be demonstrated in a range of neural and neuroendocrine tissues, including cells of the adrenal medulla and pancreatic islets. Synaptophysin can be used to identify tumours arising from these cells, such as neuroblastoma, retinoblastoma, phaeochromocytoma, carcinoid, small-cell carcinoma, and medullary thyroid carcinoma. In Immunohistochemistry, it is often used in combination with chromogranin A
The staining pattern of Synaptophysin is Cytoplasmic as shown below.
Picture 1 – Synaptophysin positivity in left temporal lobe
Synaptophysin has several different applications. Below are a few examples.
Tumour or cell type |
Synaptophysin + or - |
Pheochromocytoma |
Positive |
Neuroblastoma |
Positive |
Pineocytoma |
Positive |
Metastatic carcinoma |
Negative |